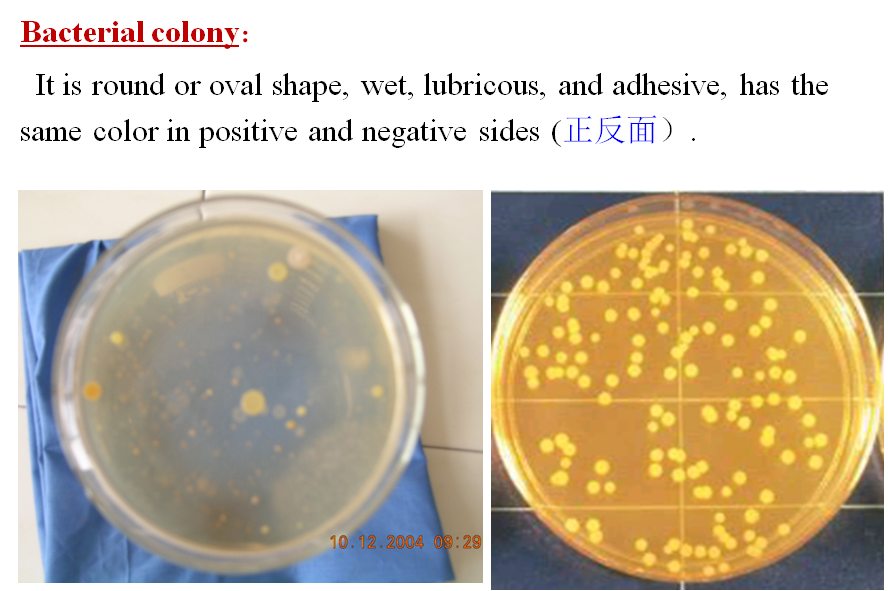

§2.1 Procaryote (原核微生物)
| category | characteristic |
Bacteria (细菌) | They are unicellular(单细胞) organisms with nuclear region(拟核), exposed DNA. |
| Filaceous bacteria (丝状菌) | Filaceous bacteria is characterised by the shapes of the threadlike. They are important in bulking of activated sludge(污泥膨胀). |
Actinomycete (放线菌) | Outstanding character is radiating forms(放射状). |
Blue bacteria (蓝绿细菌) | |
光合细菌(PSB) | In anaerobic(厌氧的) condition, it can carry out photosynthesis, using H2S (或 organics有机物),but H2O. |









2) Special structure
(1) Slime layer(粘液层), loosely clinging to cell wall;
(2) Capsule (荚膜):a thick biofilm(生物膜) which completely envelops cell wall, is adhesive substances including amylose, ploy-peptide(多肽).
Physiological(生理的) function:
① It can keep cellular inner moisture, and make itself don’t be eaten by other microorganisms;
② It stores nutriment , it is the resource of Nelement and energy ;
③ It can absorb inorganic compounds(无机物)from wastewater;
④ It increases bacteria infective(传染的) ability .